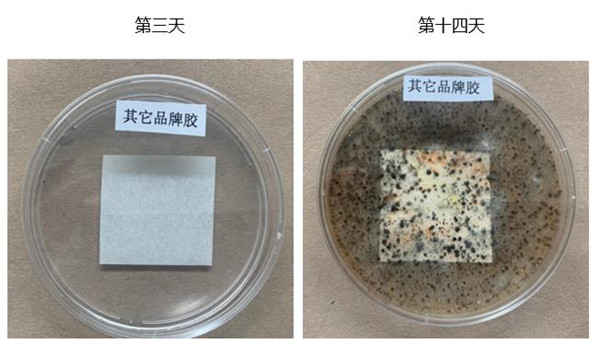

2020年,一场疫情让人们措手不及
经过一年多的不懈抗疫努力
我们取得了阶段性胜利
防疫不松懈
嘉力丰助力防疫
提升你的“免疫力”!
嘉力丰抗疫特供糯米胶来啦~
嘉力丰抑菌墙布糯米胶
让墙面拥有免疫力

墙面本身有很多细小孔洞
为细菌繁殖提供了良好的生存环境
良好的家居环境,也可以帮助我们抗疫
看得见的“干净”墙面
看不见的微小生物聚集地

细菌是墙面的主要过敏原
平均每克灰尘的细菌菌落形成
单位约为100万
墙面细菌过多,会造成以下影响

基于此,嘉力丰开发了一款
具有抗菌抑菌提高免疫力的新品
——嘉力丰抑菌墙布糯米胶
产品简介
嘉力丰抑菌墙布糯米胶是一款精选天然植物淀粉为原料,通过一系列复合变性处理生产制得的高环保性能指标的产品。本产品特别添加几十万 “纳米银”颗粒,“纳米银” 能进入细菌菌体与氧代谢酶结合,让酶失去活性阻断其代谢,具有长久抑菌、广谱抗菌、杀菌等效果,能够增加墙面的免疫力,是一款高科技产品。并且,该产品具有粘结强度高、亲水性强、低温冻融性能优异等特性,为您创造环保健康的家居生活环境。
纳米银小故事
银是一种古老的抑菌材料,大约一千年前,蒙古牧人就知道用银器皿装马奶,可使马奶不变质。银的抑菌作用主要来自银离子,对微生物的吸附作用,当微生物被银离子吸附后,其负责呼吸的酶被破坏后就会死亡。
在《本草纲目》中记载:生银,无毒;美国公共卫生局1990年《关于银毒性的调查报告》中说明:银对人体无明显毒副作用;纳米银是局部用药,银含量少,是最安全的用药方式。
纳米银抗菌产品出现在生活中的很多领域,却没有出现在墙纸墙布墙面辅料行业。
嘉力丰几十年来专注环保家装,最新研发的糯米胶采用抗菌抑菌的纳米级技术,打造墙纸墙布的超强免疫力。
产品使用范围
适用于多类墙布、墙纸,还可用于贴壁画、纸类手工、贴无纺布、贴石膏板上等。
产品核心特征
高科技纳米银、抑菌抗菌杀菌
特别添加几十万“纳米银粒子”等抑菌成分
“纳米银”能进入细菌菌体与氧代谢酶结合,让酶失去活性阻断其代谢。具备持久抑菌、广谱抗菌、杀菌的功能,能够增加墙面的免疫力,确保居家环境更健康。

纳米Ag抑菌原理图
可抑制上百种细菌
证实抗菌率达到99.99%
其中最常见的是大肠杆菌、金黄色葡萄球菌
权威检测认证
绿色环保认证
抗菌性能检测

抗菌率达到99.99%

欧盟SVHC对209项有害物质进行检测

国家化学建材质量监督检测检验中心,依据HJ2541-2016 《环境标志产品技术要求 胶黏剂》、JC/T 548-2016《壁纸胶黏剂》对产品进行检测认证。
产品实验
1
嘉力丰抑菌墙布糯米胶
十四天内抑菌对比实验
VS
条件:恒温恒室培养箱温度28度,湿度85%左右;
菌种:大肠杆菌、金黄色葡萄球菌、白色念珠菌等
结果:嘉力丰抑菌胶无细菌生长;其他品牌胶器皿周边及滤纸长满细菌。嘉力丰抑菌胶抑菌能力是其他品牌糯米胶的约3倍。
2
嘉力丰抑菌墙布糯米胶
冻融稳定性对比实验
嘉力丰抑菌墙布糯米胶,冻融循环达到8次

VS
其他品牌胶,冻融循环仅2次

健康、环保的抑菌糯米胶
吸引到你了吗?
让我们一起拥有免疫力吧!

检测到您的浏览器版本过低,
为了不影响网站的正常使用,请直接升级您的浏览器,或使用其他浏览器,如:火狐,谷歌